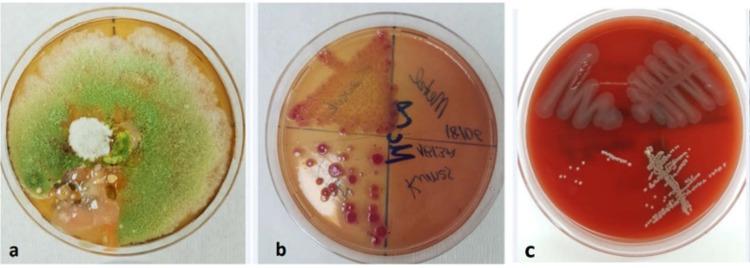
https://cdn.ncbi.nlm.nih.gov/pmc/blobs/0319/8934109/ce5afb726551/cureus-0014-00000022329-i03.jpg

对从伊斯坦布尔几个城镇获取的土壤及埋于土壤中的物证进行法医微生物学分析。
Forensic Microbiological Analysis of Soil and the Physical Evidence Buried in Soil Obtained from Several Towns in Istanbul.
作者信息
Efeoğlu Fatma Gül, Çakan Hüseyin, Kara Umut, Daş Taner
机构信息
Institute of Forensic Sciences and Legal Medicine, Istanbul University-Cerrahpaşa, Istanbul, TUR.
Department of Biology and Microbiology, Çanakkale Onsekiz Mart University, Faculty of Arts and Sciences, Çanakkale, TUR.
出版信息
Cureus. 2022 Feb 17;14(2):e22329. doi: 10.7759/cureus.22329. eCollection 2022 Feb.
Background The identification of bacterial species in the soil can be used for the differentiation of soil samples and physical evidence. This study aims to evaluate the importance of identifying microorganisms in the soil for forensic sciences. The study covered 20 regions identified and marked outside the settlement areas within the boundaries of Istanbul. Methodology Big and wide soil and forest areas were preferred. Four types of physical evidence samples were collected from the identified areas at the end of the first, second, and third months and then analyzed. The collected samples were physically embedded in the soil. In this study, 10 g of soil sample and four pieces of physical evidence (fabric, rubber, metal, and wood), sized 5 × 5 cm and buried 20-30 cm deep in the soil, contaminated with soil were collected for analysis and stored in sterile conditions. The microbiological identification analyses were conducted at the end of the predefined period and in the predefined order using first phenotypic (e.g., microscopic and macroscopic), followed by culture methods using advanced diagnostic analyses, such as API and matrix-assisted laser desorption/ionization-time of flight mass spectrometry. Results In the soil samples and the physical evidence samples collected, 83% bacteria and 17% fungus were identified. A database was set up for the study findings. Conclusions The presence of microorganisms in the soil and physical evidence samples contaminated with soil, which is crucial in the evaluation of criminal cases, was determined using microbiological analysis.
背景
土壤中细菌种类的鉴定可用于区分土壤样本和物证。本研究旨在评估鉴定土壤中的微生物对法医学的重要性。该研究涵盖了伊斯坦布尔边界内定居点以外确定并标记的20个区域。方法:优先选择广阔的土壤和森林区域。在第一个月、第二个月和第三个月末,从确定的区域收集四种类型的物证样本,然后进行分析。收集的样本被物理嵌入土壤中。在本研究中,收集了10克土壤样本和四块尺寸为5×5厘米、埋入土壤20 - 30厘米深且被土壤污染的物证(织物、橡胶、金属和木材)用于分析,并在无菌条件下储存。微生物鉴定分析在预定时间段结束时按照预定顺序进行,首先采用表型分析(如显微镜和宏观分析),然后采用先进诊断分析方法进行培养,如API和基质辅助激光解吸/电离飞行时间质谱法。结果:在收集的土壤样本和物证样本中,鉴定出83%为细菌,17%为真菌。为研究结果建立了一个数据库。结论:通过微生物分析确定了在刑事案件评估中至关重要的、被土壤污染的土壤样本和物证样本中微生物的存在。